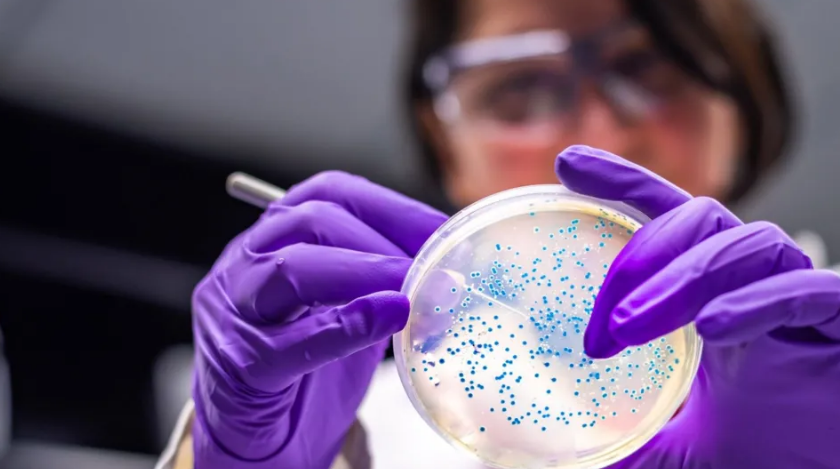

Earlier this year, scientists made headlines by repurposing a common bacterium to transform waste plastic into paracetamol, the widely used painkiller. The breakthrough is the latest example of how Escherichia coli—better known as E. coli—has become a cornerstone of biotechnology.
The microbe, often associated with food poisoning, also has non-pathogenic strains that serve as the workhorses of research and industry. Professor Stephen Wallace of the University of Edinburgh, who led the paracetamol study, has previously engineered E. coli to convert plastic into vanilla flavouring and sewer fatbergs into perfume. “If you want to prove something is possible with biology, E. coli is a natural first stage,” he explained.
The bacterium’s use goes far beyond the laboratory. For decades, large industrial vats of engineered E. coli have produced pharmaceuticals such as insulin and a range of chemicals used in fuels and solvents. Its widespread adoption stems from a long history of scientific discovery.
First isolated in 1885 by German paediatrician Theodor Escherich, E. coli proved fast-growing and easy to manipulate. In the 1940s, scientists discovered that it could exchange and recombine genetic material, a finding that propelled it to the forefront of molecular biology. It later played key roles in deciphering the genetic code and, in 1978, produced the first synthetic human insulin—solving shortages and allergic reactions linked to animal-based insulin. By 1997, E. coli had become one of the first organisms to have its genome fully sequenced.
Its dominance in biotechnology owes much to its predictability and resilience. “The more I work with more microorganisms, the more I appreciate just how robust E. coli is,” said Professor Adam Feist of the University of California, San Diego. The bacterium can thrive on many substrates, tolerate freezing and thawing, and reliably host foreign DNA.
Companies continue to rely on E. coli for industrial-scale manufacturing. “It’s very economical; you can pump out a lot,” said Dr. Cynthia Collins of Ginkgo Bioworks, though she noted that it cannot produce every compound.
However, some researchers argue that overreliance on E. coli may limit exploration of other microbes with unique capabilities. Paul Jensen of the University of Michigan pointed out that natural environments may hold bacteria capable of breaking down waste, producing new materials, or withstanding harsh conditions better than E. coli.
One emerging alternative is Vibrio natriegens, a bacterium first isolated in the 1960s and rediscovered in the past decade. With a growth rate twice that of E. coli and a greater ability to absorb foreign DNA, it has been described as a potential “next-generation” workhorse. Still, it lacks the extensive genetic tools and decades of data that support E. coli’s reliability.
As biotechnology looks to address sustainability challenges—from green fuels to rare earth mining—scientists are asking whether E. coli will continue to dominate or if new microbial stars will rise alongside it.